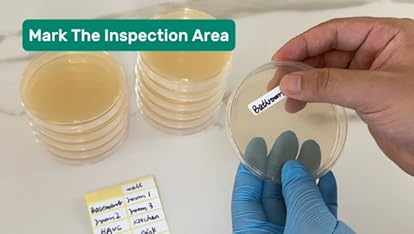
Video Widget Card

Image Unavailable
Colour:
-

-
-
- To view this video, download
Asbestos Testing DIY Kit - Canadian Lab Certified
Purchase options and add-ons
- !!! Potential 2025 Canada Post disruption !!! OUR PRE-PAID RETURN LABELS FOR YOUR SAMPLE SHIP TO OUR LAB VIA CANADA POST. TO AVOID DELAYS OR IN CASE OF URGENCY, WE STRONGLY RECOMMEND THAT YOU CONSIDER USING A COURIER SERVICE (e.g., FedEx, UPS). Please note: Our lab will not be responsible for any delays in test results caused by shipping delays due to Canada Post. Our 2-day turnaround results guarantee begins the DAY WE RECEIVE YOUR SAMPLE AT OUR LAB. Shipping times vary -- please allow up to 10 business days for our lab to receive your sample via canada post. Design 1 contact information can be found on our webpage if you have questions.
- STEP 1: Collect the sample using included personal protective equipment and following the provided instructions
- STEP 2: Fill out the chain of custody form provided
- STEP 3: Place sample in the provided bag
- STEP 4: Mail sample and completed chain of custody form to our lab using the included pre-paid envelope. ***In case of urgent scenarios, consider using a courier service with tracking***
- A detailed lab analysis report will be sent via email within 2 business days OF OUR LAB RECEIVING YOUR SAMPLE.
Product details
- Product Dimensions : 30.48 x 5.08 x 20.32 cm; 30 g
- Date First Available : Feb. 20 2025
- Manufacturer : Design 1
- Place of Business : Design 1 Environmental, Dartmouth Nova Scotia, Canada
- ASIN : B0DXVXJ9PB
- Manufacturer reference : 1
- Country of origin : Canada
- �鶹�� Rank: #4,999 in Tools & Home Improvement (See Top 100 in Tools & Home Improvement)
- #1 in Safety Test Kits
- Customer Reviews:
Videos for similar products
Product description
Asbestos Home Test Kit - Ensure Your Home's Safety. Protect your home and loved ones with our reliable Asbestos Home Test Kit. Designed for easy use, this comprehensive kit allows you to test for asbestos in various materials, such as insulation, floor tiles, and ceiling textures. ---- Why Test for Asbestos? ---- Asbestos is a known health hazard, linked to serious respiratory conditions. If your home was built before the 1980s, it's crucial to assess the presence of this dangerous material. ---- What’s Included: Sampling materials and instructions; Pre-paid shipping label for lab submission; Detailed report with lab findings. --- Our kit empowers you to take the first step in ensuring a safe living environment. Take control of your home’s safety today! ------------------ 1. General Disclaimer: This Asbestos Testing DIY Kit includes laboratory analysis to determine the presence or absence of asbestos in the submitted sample(s). This kit is intended for preliminary material testing and informational purposes only. It is not a substitute for a full site inspection, risk assessment, or professional abatement services as may be required by law. 2. Use at Your Own Risk: Sample collection involves potential exposure to hazardous materials. It is the user's responsibility to follow all recommended safety precautions, including the use of appropriate personal protective equipment (PPE) such as masks, gloves, and protective clothing. Seller assumes no liability for injury, illness, property damage, or other losses arising from the use or misuse of this kit. 3. Local Regulations and Compliance: Users are solely responsible for ensuring compliance with all applicable municipal, provincial/state, and federal regulations related to asbestos sampling, handling, transportation, and reporting. Local requirements may restrict who can collect, submit, or interpret asbestos results. Before use, users must familiarize themselves with relevant local legislation and codes of practice. 4. Laboratory Testing Limitations: Accredited laboratory analysis is performed based solely on the material submitted by the user. The accuracy of test results depends on proper sampling techniques. Improper sample collection may lead to inaccurate or inconclusive results. Neither the seller nor the laboratory assumes responsibility for errors due to user sampling methods, contamination, or misinterpretation of results. 5. No Certification or Site Clearance Provided: Laboratory analysis from this kit confirms the presence or absence of asbestos in the sample(s) submitted. It does not constitute a certified building inspection, full hazard assessment, site clearance, or compliance document under any municipal, provincial/state, or federal asbestos regulations. For regulatory clearance or legal documentation, a licensed asbestos professional must be consulted. 6. Health Risk Disclaimer: Asbestos is a hazardous material that can cause serious health effects if fibers become airborne and inhaled. Users are strongly encouraged to consult qualified environmental professionals for interpretation of results, risk assessment, and recommendations if asbestos is confirmed in the material. 7. No Warranty or Guarantee: Except as otherwise required by law, this kit is provided “as is” without warranties of any kind, either express or implied, including but not limited to warranties of merchantability, fitness for a particular purpose, or non-infringement. Seller disclaims all liability for damages resulting from the use or misuse of this product. 8. Intended Market: This kit is intended for use within Canada. Users outside of Canada are responsible for ensuring compliance with their local laws and regulations regarding asbestos sample collection, handling, and analysis.
Brands in this category on �鶹��
Product summary presents key product information
Keyboard shortcut
Shift
+
Alt
+
opt
+
D
Product Summary: Asbestos Testing DIY Kit - Canadian Lab Certified
From Generic
About this Item
- !!! Potential 2025 Canada Post disruption !!! OUR PRE-PAID RETURN LABELS FOR YOUR SAMPLE SHIP TO OUR LAB VIA CANADA POST. TO AVOID DELAYS OR IN CASE OF URGENCY, WE STRONGLY RECOMMEND THAT YOU CONSIDER USING A COURIER SERVICE (e.g., FedEx, UPS). Please note: Our lab will not be responsible for any delays in test results caused by shipping delays due to Canada Post. Our 2-day turnaround results guarantee begins the DAY WE RECEIVE YOUR SAMPLE AT OUR LAB. Shipping times vary -- please allow up to 10 business days for our lab to receive your sample via canada post. Design 1 contact information can be found on our webpage if you have questions.
- STEP 1: Collect the sample using included personal protective equipment and following the provided instructions
- STEP 2: Fill out the chain of custody form provided
- STEP 3: Place sample in the provided bag
- STEP 4: Mail sample and completed chain of custody form to our lab using the included pre-paid envelope. ***In case of urgent scenarios, consider using a courier service with tracking***
- A detailed lab analysis report will be sent via email within 2 business days OF OUR LAB RECEIVING YOUR SAMPLE.
Product description
Feedback
Did you find this product summary feature useful?